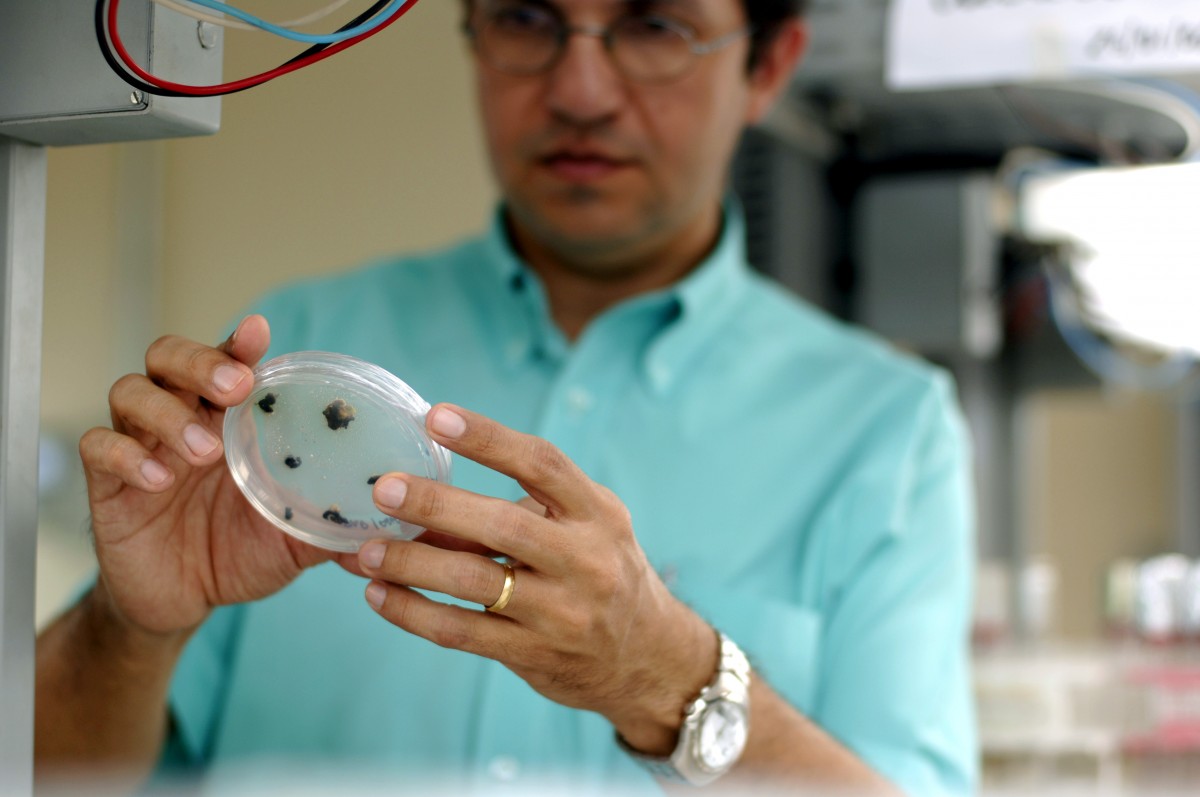

Think GMOs Aren't Regulated? Think Again
This post was originally published on Forbes on December 21, 2015.
Guest post written by Dr. Ray Dobert, Regulatory Policy Lead at Monsanto.

Each GMO seed variety takes an average of $130 million and 13 years to bring to market because of the research, safety studies and regulatory approval process necessary. (Credit: GMO Answers)
Do you want to know more about GMO regulatory policies in the United States? From my experience, many people have quite a bit of confusion about how it works, which is understandable since it’s a complicated process. Despite that confusion, GMOs go through a rigorous regulatory process to ensure they’re safe to go to market. In fact, the regulatory review process alone can take more than three years to grant approval of a new GM crop product, and overall it typically takes over 13 years for a new trait to go from an idea to the field.
Research and testing: The first steps in the regulatory process for GM crops But let’s start at the beginning: Long before developers submit genetically modified (GM) crops to U.S. regulatory agencies and other global agencies for review, they conduct many years of research and testing, regulated field trials and internal reviews of these crops.
Developers conduct extensive tests to make sure the GM crop contains the same components and levels of nutrients as its conventional varieties. Specifically, the GM crop is analyzed to make sure that, compared to conventional crops, it has similar levels of protein, carbohydrates, fat, amino acids, fiber and vitamins, as well as a variety of other components.
Any gene that is added to the GM crop is thoroughly studied and characterized. Scientists examine how the gene works, conduct environmental and ecological assessments in the lab and field, and confirm that there are no health concerns posed by the gene and/or the protein produced by the gene. This includes thorough testing to verify that any such proteins do not introduce a new food allergen. Because existing food crops are recognized as safe, the tests on the GM crop must demonstrate that it is not substantially altered from the non-GM crop in terms of its use as food or feed, or in terms of its environmental safety. This is referred to as “substantial equivalence.”
A plant scientist examines shoot and root development in GM corn tissue. GM crops undergo more testing and oversight than any other agricultural products, and the safety of biotech crops is well-established by hundreds of studies and years of real-world experience. (Credit: Monsanto)
The review process: The EPA, FDA and USDA evaluate GM crop safety
Next, GM products are examined by regulatory agencies around the world. In fact, the U.S. framework for regulation has been in place since 1986 when the Office of Science and Technology Policy (OSTP) established the “Coordinated Framework”. This policy document established the roles and responsibilities of the Environmental Protection Agency (EPA), the Food and Drug Administration (FDA), and the U.S. Department of Agriculture (USDA), and articulated how they would use existing laws related to food and feed safety, crop introduction and pesticides to regulate GMOs.
Under the Framework, the USDA evaluates whether the plant is safe to grow, the FDA evaluates whether the food derived from GM plants are safe to eat, and the EPA evaluates certain GM plants that are resistant to pests for environmental safety. Collectively these three agencies regulate all stages of the development of GM plants from initial field trials through commercialization. In addition to the safety assessments conducted by U.S. regulators, similar reviews are conducted by over a hundred regulators around the world. Only after this process is complete are farmers allowed to grow a new GM crop product in the United States.
The Coordinated Framework lays out these general principles and responsibilities for each agency:
- USDA regulates the importation, movement and confined field trials of GMOs via permitting and notification processes. Once adequate data has been collected the product developer can petition the USDA to deregulate a particular GM product.
- FDA has authority over the safety of all food, food ingredients and animal feeds. The FDA has a consultation process to assure that GM food and feed products are as safe as their conventional counterparts that are already on the market. While the consultation process with the FDA is voluntary, all of the GM products on the market have gone through this process. In addition, the FDA has the authority to recall any food or ingredient it finds is not safe for consumption.
- EPA has regulations that require evaluation and registration of all pesticidal products including GM crops, like Bt crops, that are used to repel or kill pests.
A regulatory process that evolves alongside science and government policy At the time that the Framework was established, regulators acknowledged that it should be “expected to evolve in accord with the experiences of the industry and the agencies, and, thus, modifications may need to be made.” Since then, numerous modifications and updates have been made to reflect the increased experience and familiarity with GM crops as they are grown by farmers on millions of acres. Just earlier this year, OSTP issued a call to the regulatory agencies to once again look at their policies and regulations, and with input from the public, recommend what changes might help the Framework continue to function smoothly in the coming decades.
This regulatory process continues to evolve and has proven to be effective in assessing the safety of the many GM crop products that are now available to farmers. In the nearly 20 years that these products have been on the market, they have delivered numerous benefits to growers and the environment and have not had a single documented instance of harm to human or animal health.